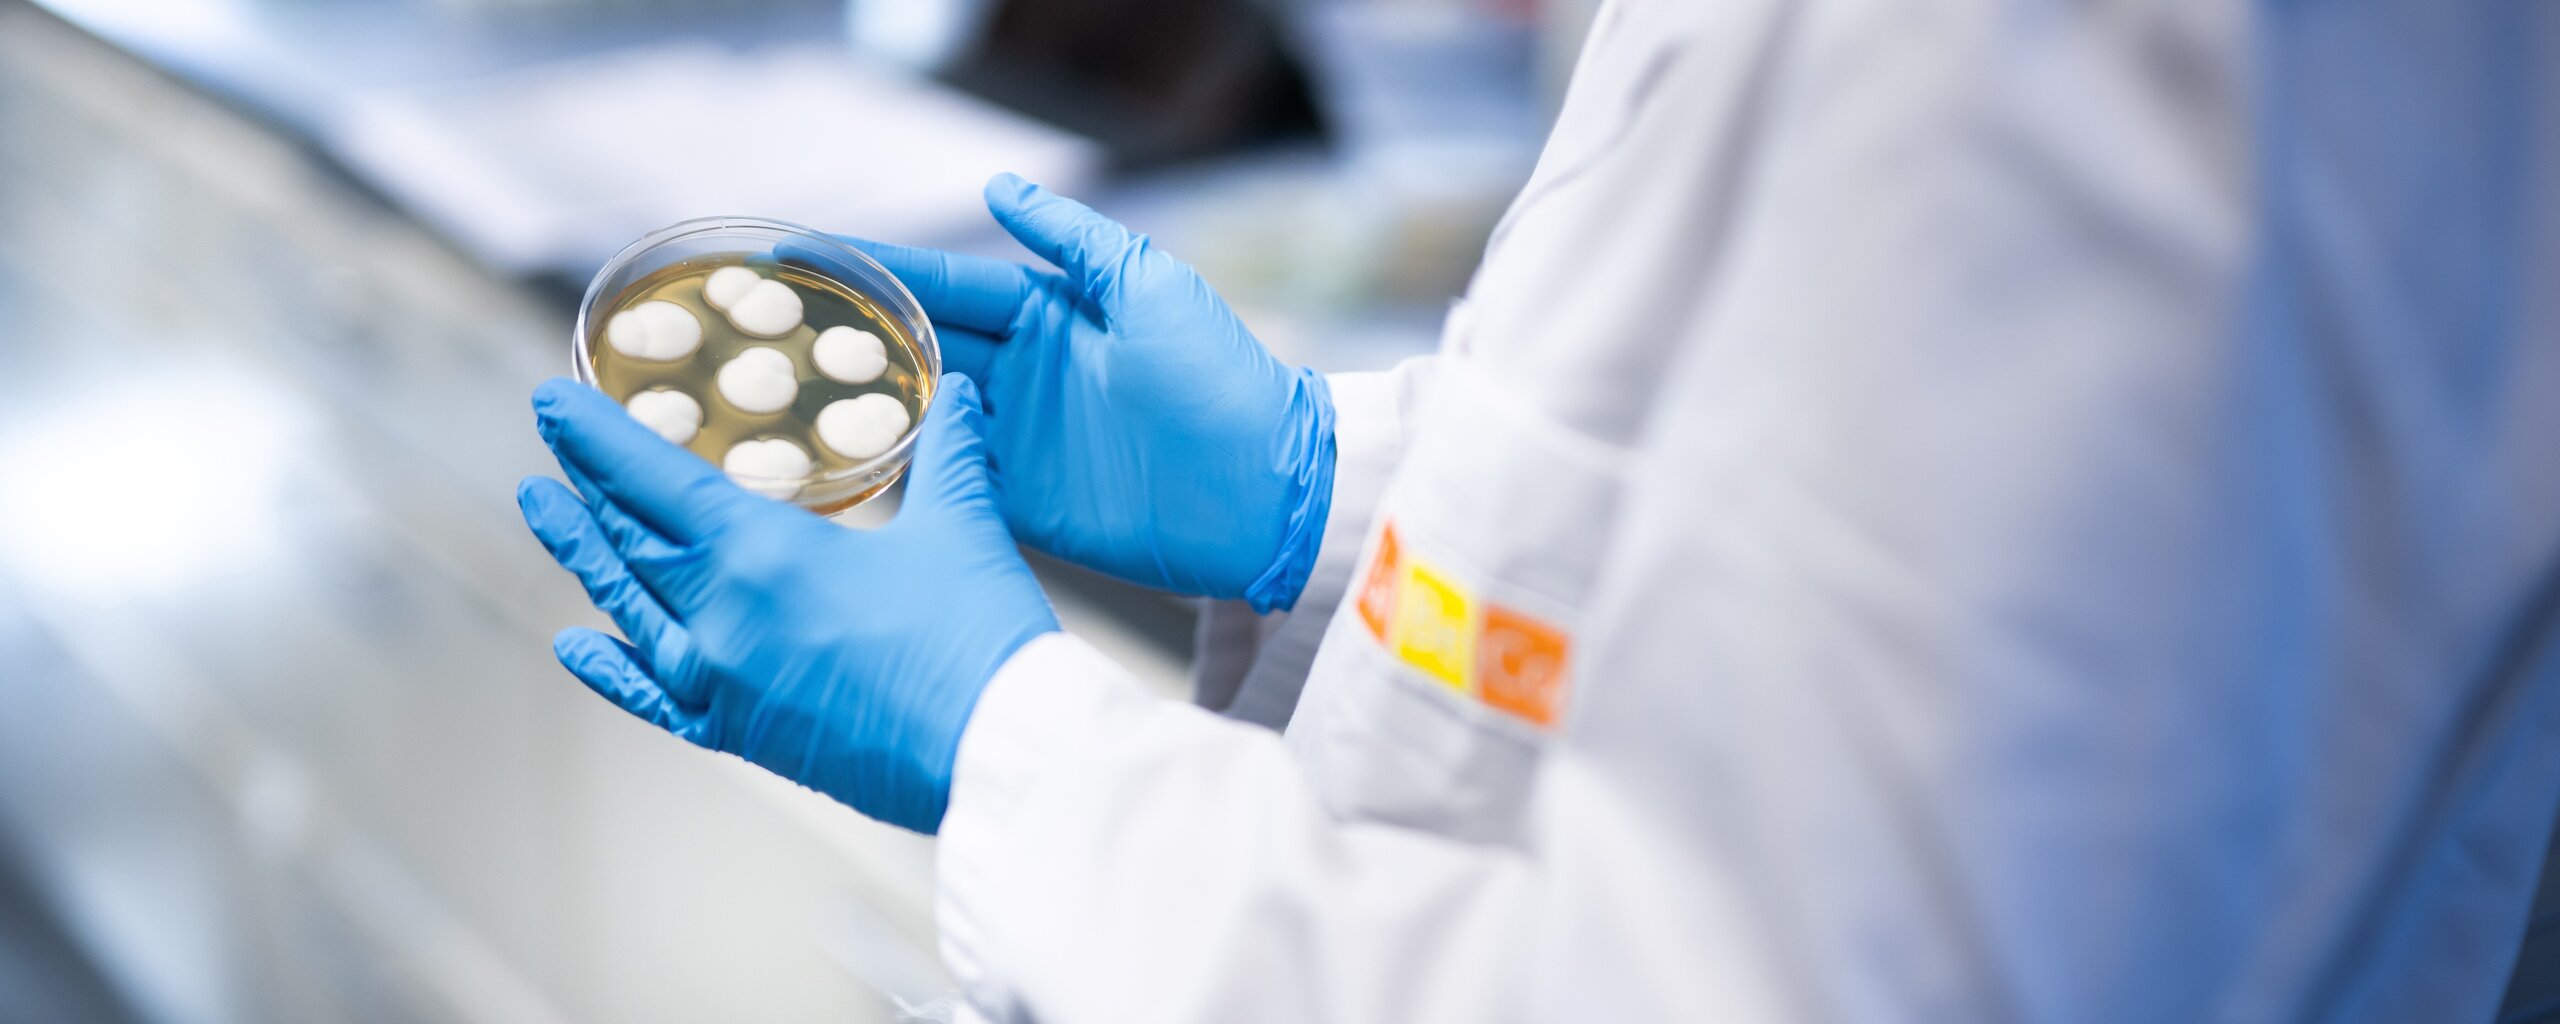

Milchproduzentenberatung
Käsereiberatung
Wasseranalytik
Leistungsverzeichnis / Probenlogistik
Auftragsrapporte
Zertifikate / Urkunden
Allgemeine Links
Gesetze und Verordnungen Lebensmittel und Gebrauchsgegenstände
Gesetze und Verordnungen Landwirtschaftliche Prodktion
Gesetze und Verordnungen Chemikalien
Zu Ihrer Suche wurden keine Treffer gefunden.